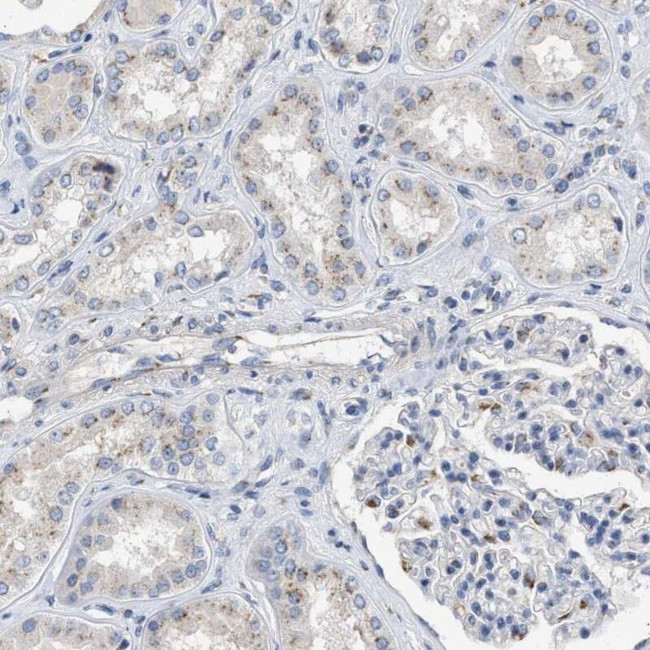
Importin 8 Antibody in Immunohistochemistry (IHC)

Search
Invitrogen
Importin 8 Polyclonal Antibody
{{$productOrderCtrl.translations['antibody.pdp.commerceCard.promotion.promotions']}}
{{$productOrderCtrl.translations['antibody.pdp.commerceCard.promotion.viewpromo']}}
{{$productOrderCtrl.translations['antibody.pdp.commerceCard.promotion.promocode']}}: {{promo.promoCode}} {{promo.promoTitle}} {{promo.promoDescription}}. {{$productOrderCtrl.translations['antibody.pdp.commerceCard.promotion.learnmore']}}

Please note: We are reviewing Western blot images included in the antibody testing data in our catalog, including those provided by third parties. Unless expressly labeled or annotated as “raw-unedited”, Western blot images included in the antibody testing data in our catalog may have been edited, optimized or otherwise adjusted for presentation.
产品信息
PA5-53801
种属反应
宿主/亚型
分类
类型
抗原
偶联物
形式
纯化类型
保存液
内含物
保存条件
运输条件
RRID
产品详细信息
Immunogen sequence: LLLHTLERIQ LPHNPGPITV QFINQWMNDT DCFLGHHDRK MCIIGLSILL ELQNRPPAVD AVVGQIVPSI LFLFLGLKQV CATRQLVNRE DRSKAEKADM EENE
Highest antigen sequence identity to the following orthologs: Mouse - 86%, Rat - 87%.
靶标信息
Importin 8 is a 1037 amino acid nuclear protein with a RAN binding site. It belongs to RAN-binding protein super family and hence shares an N-terminal sequence motif with importin-beta that appears to account for RAN GTP binding. It binds to the nuclear pore complex (NPC) and is well known as a transport carrier that mediates nuclear import of ribosomal proteins with a classical nuclear localization signal. Importin 8 works by binding to the nuclear pore complex and, along with RANGTP and RANBP1, inhibits the GAP stimulation of the RAN GTPase. Along with transportin it also helps in the nuclear import of SRP19.
仅用于科研。不用于诊断过程。未经明确授权不得转售。
篇参考文献 (0)
生物信息学
蛋白别名: FLJ26580; Imp8; Importin-8; Ran-binding protein 8; RanBP8
基因别名: IPO8; RANBP8
Entrez Gene ID: (Human) 10526